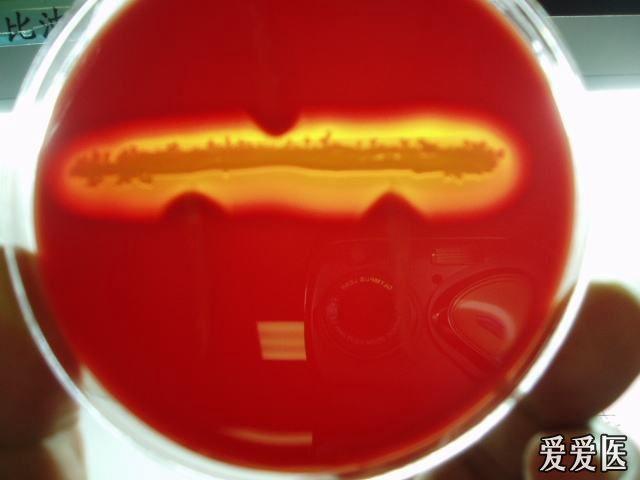
反向camp

camp实验

camp实验
图片尺寸300x290
一板 8 点足够了;于是,我在血平板上参照 camp 实验的标准画了一幅
图片尺寸354x287
反向camp
图片尺寸640x480
微生物比较经典的实验camp实验
图片尺寸1080x1439
basecamp的线下空间的7㎡策展厅,正在展出一个特殊的实验展.
图片尺寸1080x1440
七叶苷nacl试验 6.camp试验 6.杆菌肽试验 七叶苷试验(阴性或阳性)6.
图片尺寸1080x810
camp实验(初步鉴定b群链球菌的实验)_摘编百科
图片尺寸586x679
协同溶血试验 (camp) :选做项目
图片尺寸459x492
qcamp营员参观qualcomm实验室
图片尺寸1194x850
马红球菌引起肺脓肿和血流感染一例
图片尺寸218x147
camp实验阳性(b族链球菌能产生一种物质—camp因子,它能够使葡萄球菌
图片尺寸1199x1599
my summer camp
图片尺寸1599x1199
summer camp 19
图片尺寸639x480
致病性球菌之 b群链球菌 金黄色葡萄球菌 以及b群链球菌鉴定camp实验
图片尺寸980x612
李斯特的协同溶血实验
图片尺寸355x299
您知道camp实验用什么金葡菌么
图片尺寸2048x1536
人环磷酸腺苷(camp)酶联免疫elisa试剂盒
图片尺寸750x750
camp是什么实验,camp是怎么形成的(美国生物基地与病毒相关的两条时间
图片尺寸509x326
一起期待吧~97接种7种菌97camp试验97胆汁七叶苷实验#医学检验
图片尺寸1080x1078
两步完成全部实验:目标化合物刺激细胞-加入htrf试剂检测camp
图片尺寸640x286